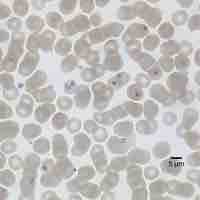
Thumbnail

Chapter 23
Protists
By Boundless

Protists are eukaryotes that first appeared approximately 2 billion years ago with the rise of atmospheric oxygen levels.

Eukaryotes, having probably evolved from prokaryotes, have more complex traits in both cell and DNA organization.

Eukaryotes may have been a product of one cell engulfing another and evolving over time until the separate cells became a single organism.

Mitochondria are energy-producing organelles that are thought to have once been a type of free-living alpha-proteobacterium.

Plastids may derive from cyanobacteria engulfed via endosymbiosis by early eukaryotes, giving cells the ability to conduct photosynthesis.

Protists are an incredibly diverse set of eukaryotes of various sizes, cell structures, metabolisms, and methods of motility.
Protists live in a wide variety of habitats, including most bodies of water, as parasites in both plants and animals, and on dead organisms.

Excavata, defined by a feeding groove that is "excavated" from one side, includes Diplomonads, Parabasalids and Euglenozoans.

Alveolates are defined by the presence of an alveolus beneath the cell membrane and include dinoflagellates, apicomplexans and ciliates.

Stramenophiles include photosynthetic marine algae and heterotrophic protists such as diatoms, brown and golden algae, and oomycetes.

Rhizaria are a supergroup of protists, typically amoebas, that are characterized by the presence of needle-like pseudopodia.

Archaeplastida are a supergroup of protists that comprise red and green algae, which include unicellular, multicellular, and colonial forms.

Amoebozoa are a type of protist that is characterized by the presence of pseudopodia which they use for locomotion and feeding.

Protists function as sources of food for organisms on land and sea.
Many protists exist as parasites that infect and cause diseases in their hosts.

Many protists act as parasites that prey on plants or as decomposers that feed on dead organisms.